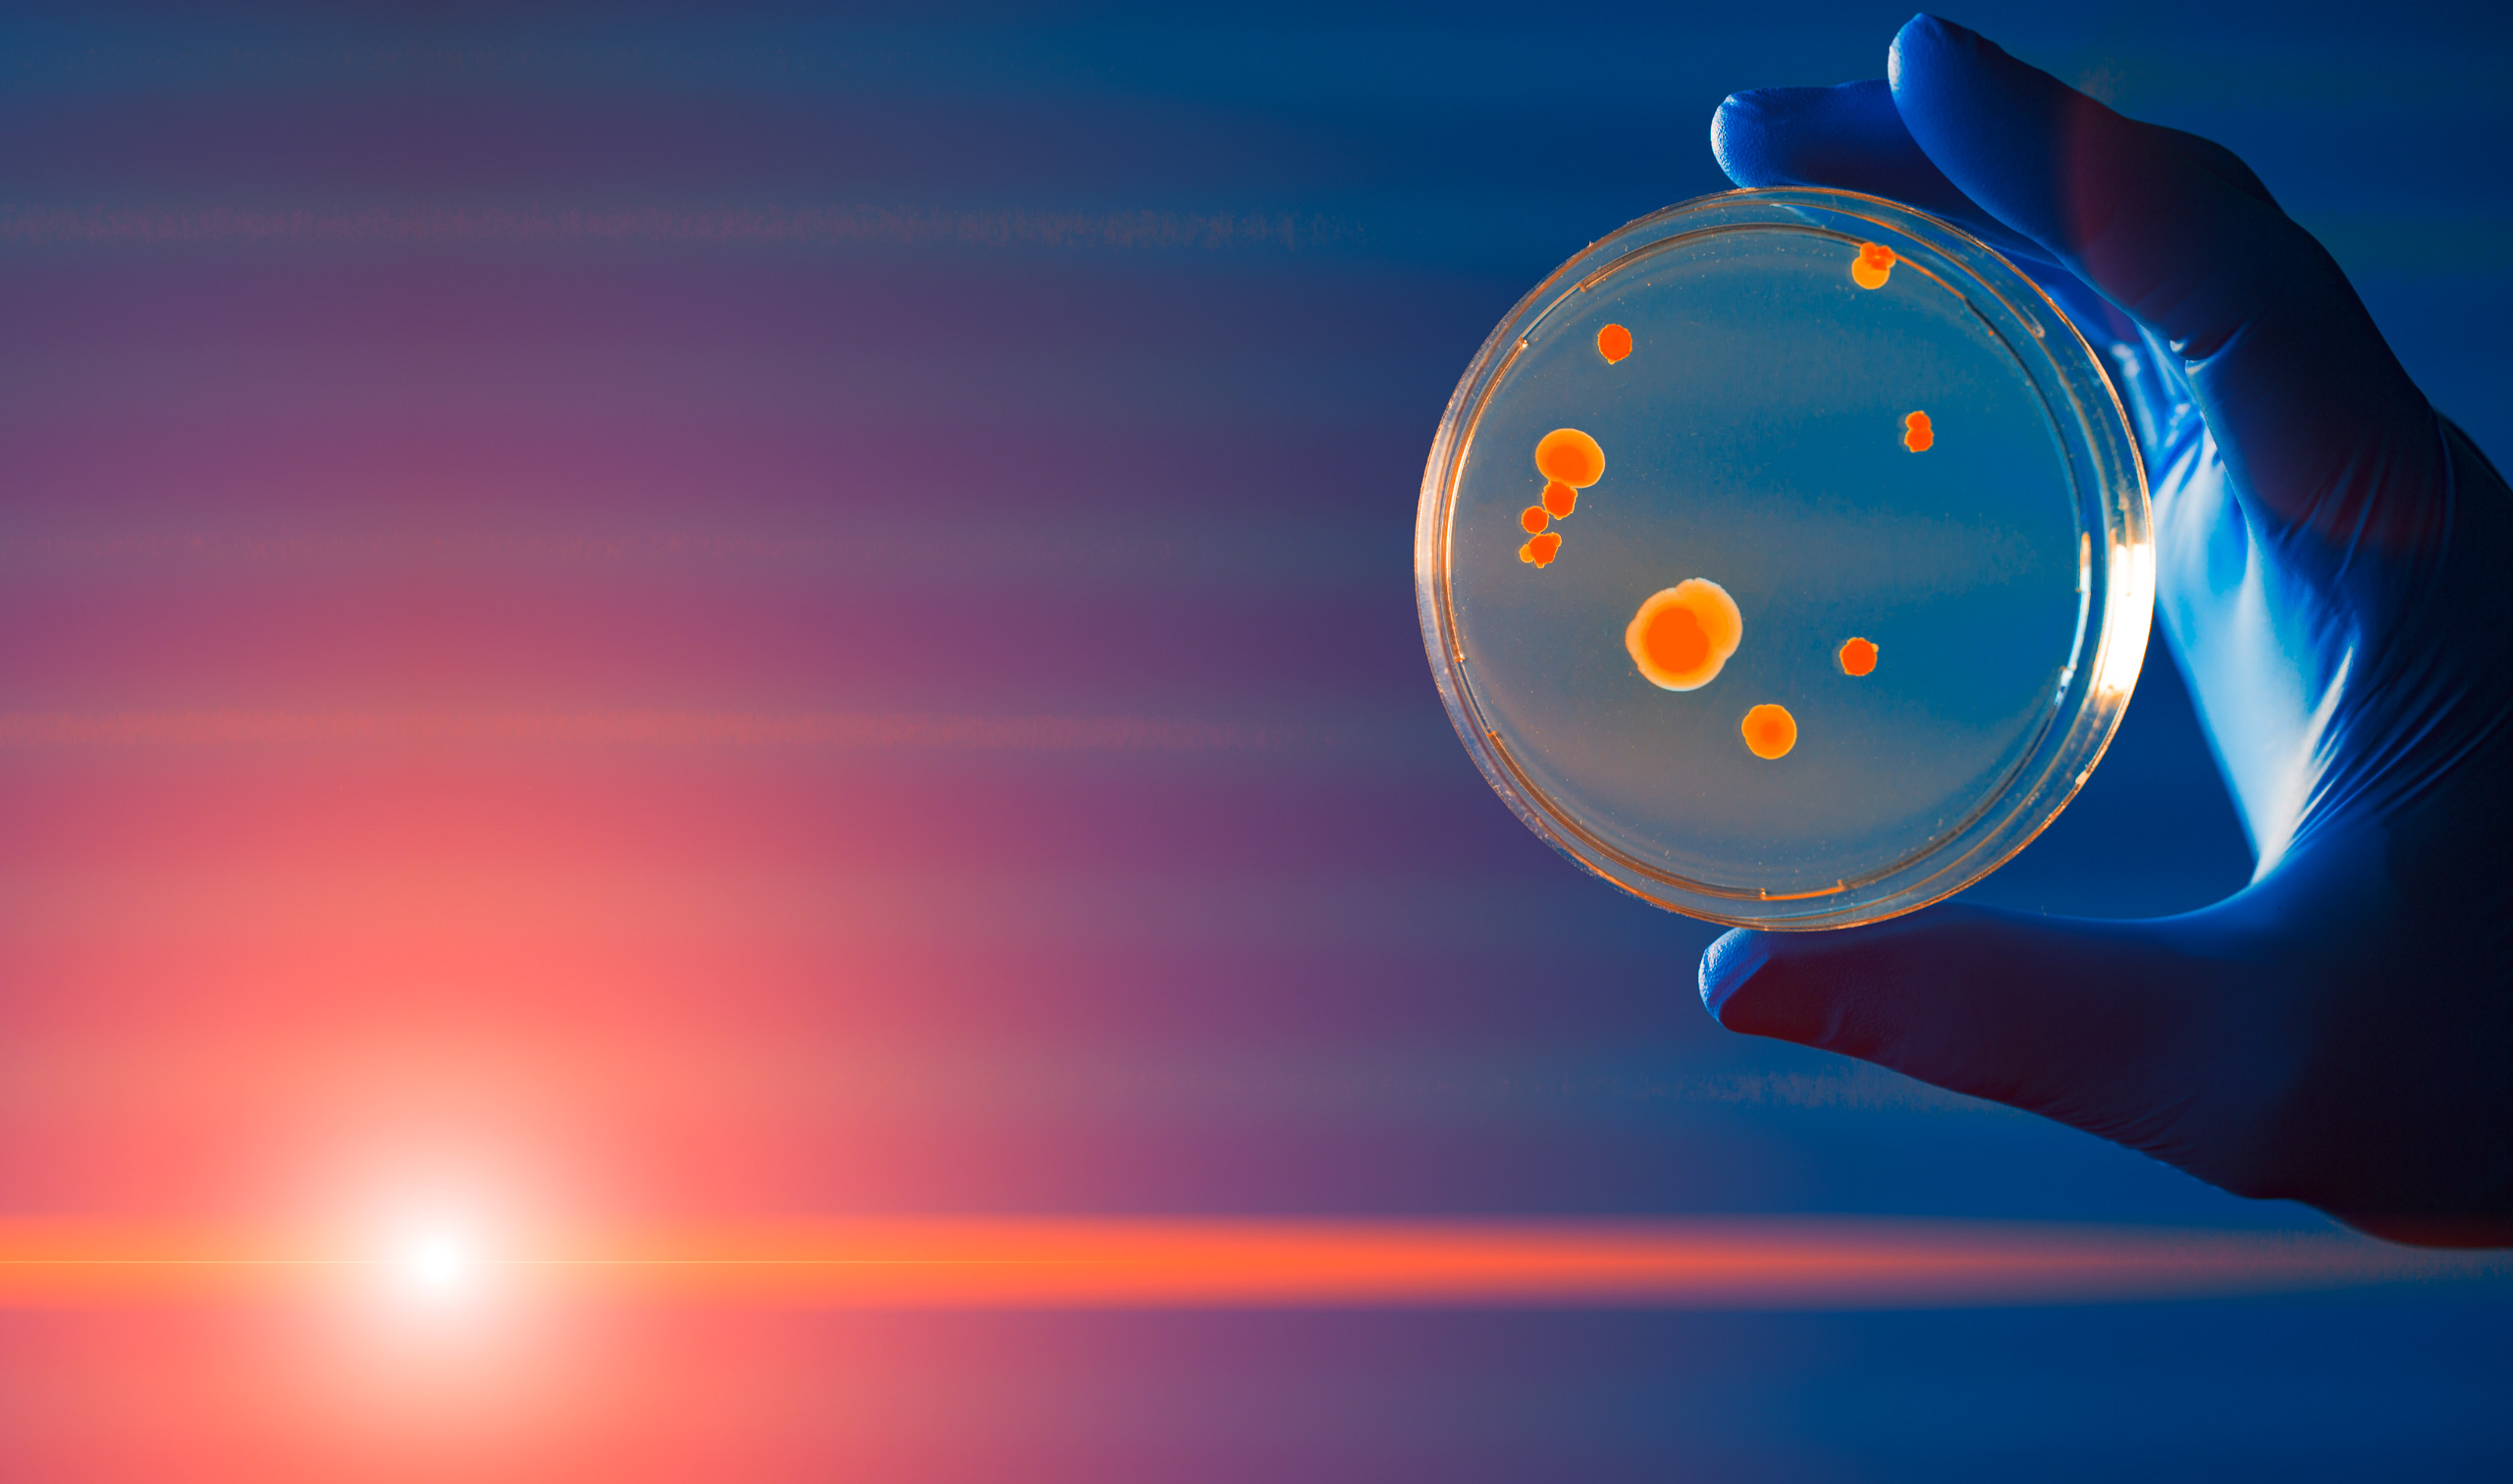

Zellkulturmedien
Mit der richtigen Anlage zur perfekten Zellperformance
Zellkulturen benötigen spezifische Medien. Die Kunst, gute Zellvitalität und Wachstumskurven zu erzeugen, liegt in der Rezeptur und der korrekten Formulierung der Inhaltsstoffe. Nachdem diese Mischung gefunden ist, spielt die richtige Verarbeitung eine entscheidende Rolle. Das Trockenmedium muss sowohl in seiner Korngröße als auch im Mischungsverhältnis homogen sein, um sich nicht nur schnell zu lösen, sondern auch in jeder Einzeldosis die gleiche und richtige Zusammensetzung zu enthalten. Durch eine schonende und hygienische Verarbeitung der Zellkulturmedien wird deren hohe Qualität gewährleistet. Dabei müssen die Produktionsanlagen flexibel und effizient sein, um täglich neue Batches herstellen zu können. Dies impliziert selbstverständlich eine einfache und schnelle Reinigung.
- Kernprozesse Mischung und Mahlung aus einer Hand
- Gekühlte Feinmahlung in der Hosokawa Alpine Feinprallmühle
- Schonende zugleich intensive Mischung im konischen Nauta Mischer
- Integrierte, automatische Anlagenreinigung
- Höchster Automatisierungsgrad
Vertikale Auslegung der Maschinenanordnung
Hohes Maß an Flexibilität für eine Vielzahl von Formulierungen
Eine große Herausforderung beim Ansetzen von Zellkulturmedien liegt in der nahezu unbegrenzten Anzahl von Rezepturen mit vielen verschiedenen Komponenten, unterschiedlicher Schüttdichte, Partikelgröße oder Fließfähigkeit. Dies erfordert ein universelles System, das alle Prozessschritte von der Formulierung über das Vormischen, Vermahlen und Nachmischen bis hin zum Verpacken beinhaltet.
Die Technologie der Hosokawa Group setzt unmittelbar nach der Formulierung an und integriert die Kerntechnologien Mischen und Mahlen in einem nahtlosen Prozess. So sorgt sie für eine hochwertige Medienqualität.
Im Vormischer werden die Komponenten der Medienrezeptur gleichmäßig verteilt und diese Mischung auch während der Dosierung auf die Mühle nicht entmischt. In der Mühle werden die verschiedenen Materialien auf eine einheitliche Korngröße zerkleinert und direkt in einen zweiten Mischer befördert. Hier können noch kleinste Mischungsanteile zur Finalisierung des Produkts beigegeben werden. Mit diesem Mischer wird eine hochwertige Homogenisierung des gesamten Batchs erreicht und während des gesamten Verpackungsvorgangs aufrecht erhalten.
Dadurch kann im letzten Schritt durch die kontaminationsfreie Verpackungseinheit vom ersten bis zum letzten Container eine einheitliche Produktqualität erzeugt werden. Diese vertikale Auslegung der Maschinenanordnung ermöglicht eine einfache Produktführung und reduziert den Reinigungsaufwand. Da keine Fördersysteme benötigt werden, fällt auch der apparative Aufwand geringer aus.
Zudem bringt diese Maschinenanordnung eine maximal Materialausbeute sowie ein hohes Maß an Flexibilität für eine Vielzahl von Formulierungen mit sich:
- Inertes System mit geschlossenem Kreislauf (95% Stickstoff-Ersparnis)
- Temperaturgesteuertes Mahlen (bis zu -40 °C)
- Hohe Mischgenauigkeit
- Geschlossene Verarbeitung, von der Aufgabe bis zur Verpackung
- Integrierte Reinigung
Schonende und zugleich intensive Mischung
Höchste Mischgenauigkeit ohne Kontamination
Der konische Nauta-Schneckenmischer unseres niederländischen Partners Hosokawa Micron B.V.arbeitet durch seine konvektive Technik äußerst schnell und effizient. Dadurch vermengt er das Mischgut bei maximaler Genauigkeit schonend, ohne die Struktur zu beschädigen.
Um Kreuzkontaminationen zwischen den Chargen zu vermeiden, wurde der Nauta-Mischer konsequent nach Hygienestandards und GMP-Vorgaben konstruiert.
Entscheidende Vorteile des Nauta-Mischers:
- Maximale Mischgenauigkeit
- Kontinuierlich hohe Homogenität der Produktqualität
- Schonendes und strukturerhaltendes Mischen
- Flexible Chargengrößen zwischen 15 und 100 %
- Hygienisches Design für ausgezeichnete Reinigung
- Kontinuierlich homogenes Produkt am Austrag
- Energetisch hochoptimiertes Mischkonzept

Gekühlte Feinmahlung in der Hosokawa Alpine Feinprallmühle
Feinstvermahlung von anspruchsvollen Materialien

Mit den Feinvermahlungslösungen von Hosokawa Alpine lassen sich auch klebende oder brückenbildende Produkte hervorragend verarbeiten. Bei temperaturempfindlichen Zellkulturmedienbestandteilen ist höchste Produktqualität ebenfalls garantiert.
Die Feinprallmühle UPZ deckt einen Bereich von etwa 20 bis 1500 μm ab. Für diesen Mühlentyp ist eine Vielzahl von Mahleinsätzen erhältlich – je nachdem, um welches Produkt es sich handelt und welche Korngröße erzielt werden soll.
Bei der Herstellung von Zellkulturmedien wird die UPZ-Mühle üblicherweise mit Stiftscheiben für feinst vermahlene und homogene Produkte von 20 - 150 μm ausgestattet. Das gemahlene Produkt weist eine steile Partikelgrößenverteilung auf und lässt dadurch hervorragend mischen.
Für die Formulierung spezieller Zellkulturmedien eignet sich die Stiftmühle Contraplex CW II mit gegenläufigen Stiftscheiben und der Option zur Tieftemperaturvermahlung mit LN2-Kühlung (bis -40 °C). Da der Stickstoff hier im Kreisgasbetrieb zugeführt wird, reduziert sich der Stickstoffverbrauch im Vergleich zum Durchgasbetrieb um 95%. Zudem erhöht sich dadurch die Produktqualität: Das Produkt kann besser gelagert werden und es kommt zu keiner Kontamination durch die Umgebungsluft. Auch Oxidation oder Feuchtigkeitseintrag werden verhindert.
Entscheidende Vorteile der Alpine Feinprallmühle:
- Steile Korngrößenverteilung
- Vermahlen unter niedrigen Temperaturen
- Hygienisches Design für ausgezeichnete Reinigung
- Verkürzte Durchlaufzeiten und Downtimes
Integrierte, automatische Anlagenreinigung
Sauber & startklar - nach jedem Batch
Systeme zum Ansetzen von Zellkulturen müssen flexibel und effizient sein, wenn täglich neue Chargen mit unterschiedlichen Rezepturen hergestellt werden sollen. Bei der Auswahl der geeigneten Prozessausrüstung spielen die Reinigungsmöglichkeiten daher eine entscheidende Rolle.
Durch die automatisierte Reinigung der Anlagen der Hosokawa Micron Group lassen sich dauerhafte und reproduzierbare Reinigungsergebnisse erzielen. Zudem reduzieren sich die Stillstandzeiten der Anlage ebenso wie Fehler – egal, ob es sich um Bedienungs- oder Reinigungsfehler handelt. Im Vergleich zur manuellen Reinigung ist diese Form der Anlagenreinigung besser planbar. All dies macht den Einsatz der Hosokawa-Anlagen ressourcenschonend, sowohl in personeller als auch in materieller Hinsicht.
Die vertikale, aseptische Auslegung mit einer hochwertigen Oberflächengüte und die konischen Mischbehälter mit der festen Verbindung zur Mühle garantieren zudem eine maximale Produktrückgewinnung.
Um auch die letzten Produktrückstände aus dem System zu entfernen, werden zur Nassreinigung Sprühdüsen eingesetzt, die durch ihre Positionierung eine validierte Reinigung auch an kritischen Stellen gewährleistet. Nach der Nassreinigung werden alle Bauteile mit Heißluft getrocknet.
Ein automatisierter Ablauf macht die Reinigung der Anlagen validierbar.

Zuverlässige Automatisierung unter pharmazeutischen Standards
Höchster Automatisierungsgrad
Die Steuerung der Produktionslinie erfolgt über ein vollautomatisches Steuerungssystem, das pharmazeutischen Standards wie FDA, cGMP und GAMP entspricht. Das System kann bis zur Abpackung autark laufen, sodass der Operator entlastet wird und nicht in die Produktion eingreifen muss. Zugleich ermöglicht die Automatisierung Predictive Maintenance.
Sicher vom Labor zur Produktion
Hervorragende Scalability
Die Anlagenkonfiguration der Hosokawa Micron Group ist sowohl im Labor als auch in der Produktion nutzbar, da die Prozesse über die verschiedenen Anlagengrößen identisch sind. So ergibt sich ein sicherer Scale-up von der Laboranlage auf die Produktion. Bei Parallelbetrieb von Labor und Produktionsanlage ist ein Wechsel vom Labormuster auf Produktionsmaßstab innerhalb weniger Minuten möglich. Das bedeutet eine maximale Auslastung der Hauptanlage
- Bedarfsgerechte Produktplanung
- Schnelle, flexible Produktentwicklung mit kurzen Zeiten von der Produktentwicklung bis zur Produktion
- Größere Bandbreite an Rezepturen
- Zuverlässige Produktqualität in verschiedensten Batchgrößen

Perfekt aufeinander abgestimmte Anlagenkomponenten sind unsere Kernkompetenzen
Komplettlösungen aus einer Hand

Sie erhalten eine optimal abgestimmte und auf Ihre Anforderungen angepasste Anlage!
Übergreifenden Rezeptverwaltung über die gesamte Prozesskette und das Erstellen von Batchreports sind dabei problemlos möglich.
Weitere Vorteile:
- Einfache Bedienung
- Optimal abgestimmte Serviceleistungen
- Kurze Downtimes
- Einheitliche Dokumentation
Mit uns als Komplettanbieter verkürzt sich die Projektlaufzeit um ca. 10–30 % gegenüber Projekten bei denen Komponenten unterschiedlicher Anbieter aufeinander abgestimmt werden müssen.
Zuverlässige Lösungen für Zellkulturmedien durch integrierte Systeme
Von der Vormischung bis zur Verpackung
Entscheidend ist die Verarbeitung – von der Vormischung bis zur Verpackung – in einem durchgängigen Prozess. Ein integrierter Ansatz zur Prozesslösung ist essenziell. Er verhindert den ungewollten Kontakt mit Sauerstoff, Feuchtigkeit und Keimen der Umgebung. Kurze Verarbeitungszeiten unter konditionierten, kühlen Bedingungen sichern die Qualität der Inhaltsstoffe. Ein hoherAutomatisierungsgrad im Prozess – insbesondere bei Reinigung und Trocknung – schafft Sicherheit und Flexibilität und ermöglicht die Herstellung verschiedenster Medien auf einer Anlage, ganz gleich ob in Batchgrößen von wenigen Kilogramm oder im Tonnenmaßstab.
Der Hosokawa Alpine Prozess zur Herstellung von Trockenmedien für Zellkulturen ist schon heute zum Industriestandard geworden und ein Garant für hochwertige Medienqualität.
Die etablierten Produktionsprozesse bieten Sicherheit bei der Investition und Kunden können sich ganz auf ihr Produkt und die Formulierung konzentrieren,
ohne sich mit den Details der Anlage auseinandersetzen zu müssen.
für die Produktion